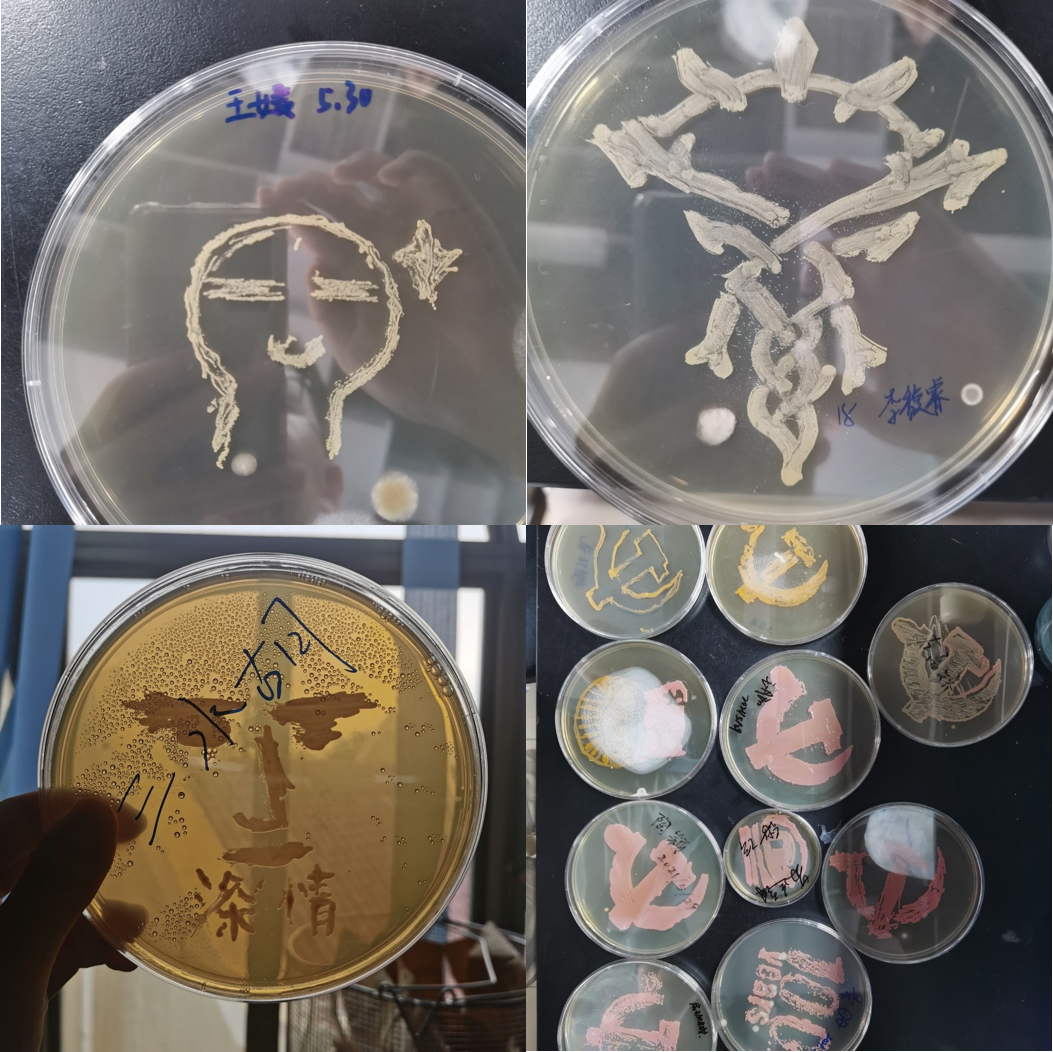
图片

5月30日至6月7日,由共青团开云电竞网址委员会主办、共青团开云电竞网址海洋生命学院委员会承办的开云电竞网址第三十四届大学生科技文化节之海洋生命学院“微生物的红色映画”科学实践课堂活动顺利举行。本次活动分为“理论学习”“实践操作”“作品培养”“优秀评选”四个环节,其中,活动的前两个环节在鱼山校区生物基础实验中心308微生物实验室进行。海洋生命学院团委辅导员张文博、海洋生命学院科技协会部分成员,以及来自海洋生命学院、水产学院、医药学院和食品科学与工程学院的部分同学参加了本次活动。
|| 合影||
活动伊始,海洋生命学院本科2019级生物科学专业的侯铎向大家阐明了本次活动的目的和意义。本次活动的主要内容是以微生物作画的形式将“中国共产党党徽”“100”等图案呈现出来,号召同学们将党史学习教育与趣味实验操作有机结合,激励大家通过自己的专业知识向中国共产党成立100周年献礼。
随后,海洋生命学院本科2019级生物科学专业郭佳美、李若萱等同学以操作演示的方式向同学们展示了微生物实验操作的基本方法与要领,向同学们介绍了所用菌种的生长特性、培养条件和微生物绘画过程中可能会出现的问题。
||“理论学习”环节||
通过理论知识的学习后,同学们开始着手于科学创作。大家以提前印制准备的图案为模板进行了规定作品的制作,同时也自己动手绘制模板进行自选作品的制作,活动科研助手在一旁对同学们的实验操作认真给予了建议与协助。
||“实践操作”环节||
同学们创作的作品在微生物培养箱中进行了一段时间培养后,6月6日,活动承办单位对作品进行了优秀评选,景丹丹、王丹阳、陶颖三名同学的作品获得规定作品优秀奖,陈世湖、李馥睿、王媛三名同学的作品获得自选作品优秀奖,获奖同学获赠鱼骨标本,以资鼓励。
至此,本次开云电竞网址第三十四届大学生科技文化节之海洋生命学院“微生物的红色映画”科学实践课堂活动圆满结束。
以下是本次活动的优秀作品展示:
图文 | 张文博 侯铎
编辑 | 张妮
责编 |张妮
审核 | 张文博